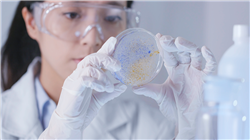
##IMAGE##

University certificate
The world's largest faculty of veterinary medicine”
Introduction to the Program
A unique and up-to-date program that will boost your profile in the field of Clinical Trials in just a few weeks"

Clinical Trials are carried out on species in multiple fields, from domestic animals to those destined for production and consumption. For these areas, the knowledge that a professional must have is very specific and requires advanced skills that are increasingly in demand in an area as relevant as this in the labor market.
This is the reason why the best university in the world has included among its offerings a Postgraduate certificate in Veterinary Clinical Trials in Laboratories and Farms to provide students with specific skills with which to carry out their work as efficiently as possible. And this, through a syllabus that delves into aspects such as the Interaction between Animals and their Environment, the Adaptation of Protocols, Planning according to the Place of Study or Working Conditions, among other relevant topics.
All this, in a 100% online modality that greatly facilitates the study process of the students, allowing them to advance without seeing repercussions on their other responsibilities and getting through the plan of studies in a short period. In addition, with the most up-to-date and complete theoretical and practical materials on the market.
A program designed to help you achieve excellence in the field of Clinical Trials in Laboratories and Farms"
This Postgraduate certificate in Veterinary Clinical Trials in Laboratories and Farms contains the most complete and up-to-date scientific program on the market. Its most notable features are:
- The development of case studies presented by experts in Veterinary Clinical Trials in Laboratories and Farms.
- The graphic, schematic, and practical contents with which they are created, provide scientific and practical information on the disciplines that are essential for professional practice
- Practical exercises where self-assessment can be used to improve learning
- Its special emphasis on innovative methodologies
- Theoretical lessons, questions to the expert, debate forums on controversial topics, and individual reflection assignments
- Content that is accessible from any fixed or portable device with an Internet connection
You will work with the most exhaustive information on Clinical Trials in Companion Animals, in the field of Poultry or Swine"
The program’s teaching staff includes professionals from the field who contribute their work experience to this educational program, as well as renowned specialists from leading societies and prestigious universities.
The multimedia content, developed with the latest educational technology, will provide the professional with situated and contextual learning, i.e., a simulated environment that will provide immersive education programmed to learn in real situations.
This program is designed around Problem-Based Learning, whereby the professional must try to solve the different professional practice situations that arise during the educational year. For this purpose, the students will be assisted by an innovative interactive video system created by renowned and
experienced experts.
You will be able to access all the content from the first day and with any device with an Internet connection, whether it is a tablet, cell phone, or computer"
A program that will enhance your skills and allow you to excel in the area of Clinical Trials in just a few weeks"
Why study at TECH?
TECH is the world’s largest online university. With an impressive catalog of more than 14,000 university programs available in 11 languages, it is positioned as a leader in employability, with a 99% job placement rate. In addition, it relies on an enormous faculty of more than 6,000 professors of the highest international renown.

Study at the world's largest online university and guarantee your professional success. The future starts at TECH”
The world’s best online university according to FORBES
The prestigious Forbes magazine, specialized in business and finance, has highlighted TECH as “the world's best online university” This is what they have recently stated in an article in their digital edition in which they echo the success story of this institution, “thanks to the academic offer it provides, the selection of its teaching staff, and an innovative learning method aimed at educating the professionals of the future”
A revolutionary study method, a cutting-edge faculty and a practical focus: the key to TECH's success.
The most complete study plans on the university scene
TECH offers the most complete study plans on the university scene, with syllabuses that cover fundamental concepts and, at the same time, the main scientific advances in their specific scientific areas. In addition, these programs are continuously being updated to guarantee students the academic vanguard and the most in-demand professional skills. In this way, the university's qualifications provide its graduates with a significant advantage to propel their careers to success.
TECH offers the most comprehensive and intensive study plans on the current university scene.
A world-class teaching staff
TECH's teaching staff is made up of more than 6,000 professors with the highest international recognition. Professors, researchers and top executives of multinational companies, including Isaiah Covington, performance coach of the Boston Celtics; Magda Romanska, principal investigator at Harvard MetaLAB; Ignacio Wistumba, chairman of the department of translational molecular pathology at MD Anderson Cancer Center; and D.W. Pine, creative director of TIME magazine, among others.
Internationally renowned experts, specialized in different branches of Health, Technology, Communication and Business, form part of the TECH faculty.
A unique learning method
TECH is the first university to use Relearning in all its programs. It is the best online learning methodology, accredited with international teaching quality certifications, provided by prestigious educational agencies. In addition, this disruptive educational model is complemented with the “Case Method”, thereby setting up a unique online teaching strategy. Innovative teaching resources are also implemented, including detailed videos, infographics and interactive summaries.
TECH combines Relearning and the Case Method in all its university programs to guarantee excellent theoretical and practical learning, studying whenever and wherever you want.
The world's largest online university
TECH is the world’s largest online university. We are the largest educational institution, with the best and widest online educational catalog, one hundred percent online and covering the vast majority of areas of knowledge. We offer a large selection of our own degrees and accredited online undergraduate and postgraduate degrees. In total, more than 14,000 university degrees, in eleven different languages, make us the largest educational largest in the world.
TECH has the world's most extensive catalog of academic and official programs, available in more than 11 languages.
Google Premier Partner
The American technology giant has awarded TECH the Google Google Premier Partner badge. This award, which is only available to 3% of the world's companies, highlights the efficient, flexible and tailored experience that this university provides to students. The recognition as a Google Premier Partner not only accredits the maximum rigor, performance and investment in TECH's digital infrastructures, but also places this university as one of the world's leading technology companies.
Google has positioned TECH in the top 3% of the world's most important technology companies by awarding it its Google Premier Partner badge.
The official online university of the NBA
TECH is the official online university of the NBA. Thanks to our agreement with the biggest league in basketball, we offer our students exclusive university programs, as well as a wide variety of educational resources focused on the business of the league and other areas of the sports industry. Each program is made up of a uniquely designed syllabus and features exceptional guest hosts: professionals with a distinguished sports background who will offer their expertise on the most relevant topics.
TECH has been selected by the NBA, the world's top basketball league, as its official online university.
The top-rated university by its students
Students have positioned TECH as the world's top-rated university on the main review websites, with a highest rating of 4.9 out of 5, obtained from more than 1,000 reviews. These results consolidate TECH as the benchmark university institution at an international level, reflecting the excellence and positive impact of its educational model.” reflecting the excellence and positive impact of its educational model.”
TECH is the world’s top-rated university by its students.
Leaders in employability
TECH has managed to become the leading university in employability. 99% of its students obtain jobs in the academic field they have studied, within one year of completing any of the university's programs. A similar number achieve immediate career enhancement. All this thanks to a study methodology that bases its effectiveness on the acquisition of practical skills, which are absolutely necessary for professional development.
99% of TECH graduates find a job within a year of completing their studies.
Postgraduate Certificate in Veterinary Clinical Trials in Laboratories and Farms
Are you ready to take your veterinary career to the next level? Discover our Postgraduate Certificate Postgraduate Certificate in Veterinary Clinical Trials in Laboratories and Farms from TECH Global University. Take advantage of the convenience of online classes and expand your knowledge and skills in the exciting field of clinical trials. We understand that clinical trials are critical to the advancement of veterinary medicine, and for that reason, we have created this specialized program that focuses on clinical trials performed in laboratories and farms to give you greater tools and better veterinary treatments. Online classes give you the flexibility to learn at your own pace and from anywhere. Whether you have a busy schedule or live far from campus, our online classes allow you to access the Postgraduate Certificate content at your convenience. Plus, you'll enjoy additional benefits such as the ability to review lessons as often as you wish and the opportunity to interact with experts in the field and other students from around the world.
Learn all the clinical trial tools to improve the lives of pets
In this Postgraduate Certificate, you'll dive into the fundamentals of veterinary clinical trials, from study planning and design to data collection and analysis. You'll learn about the ethical and regulatory standards that govern clinical trials, as well as the latest trends and technologies used in the field. Our team of highly trained and experienced faculty will guide you through the program, providing you with advanced theoretical and practical knowledge to apply in your career. In addition, you will have access to cutting-edge resources, real-world case studies and interactive activities to help you consolidate your learning. Take the first step towards a successful career in the field of veterinary clinical trials. Join our Postgraduate Certificate in Veterinary Clinical Trials in Laboratories and Farms and develop the skills you need to excel in this exciting field. Enroll now and expand your horizons in veterinary medicine!







